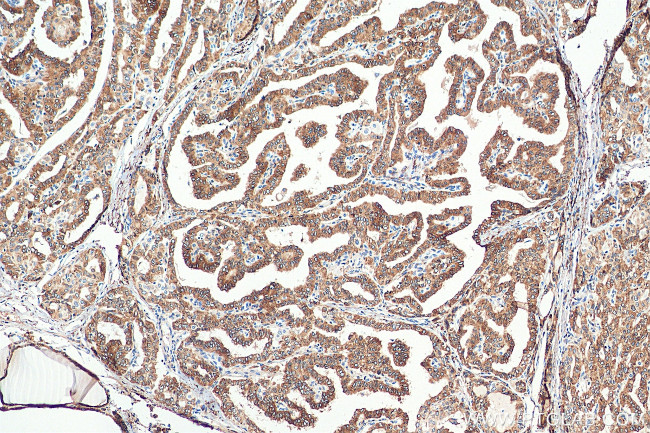
METTL7A Antibody in Immunohistochemistry (Paraffin) (IHC (P))

Search
Proteintech
METTL7A Monoclonal Antibody (1A9B4)
{{$productOrderCtrl.translations['antibody.pdp.commerceCard.promotion.promotions']}}
{{$productOrderCtrl.translations['antibody.pdp.commerceCard.promotion.viewpromo']}}
{{$productOrderCtrl.translations['antibody.pdp.commerceCard.promotion.promocode']}}: {{promo.promoCode}} {{promo.promoTitle}} {{promo.promoDescription}}. {{$productOrderCtrl.translations['antibody.pdp.commerceCard.promotion.learnmore']}}
产品信息
67905-1-IG
种属反应
宿主/亚型
分类
类型
克隆号
抗原
偶联物
形式
浓度
纯化类型
保存液
内含物
保存条件
运输条件
产品详细信息
Aliquoting is unnecessary for -20°C storage.
靶标信息
MettL7A belongs to the methyltransferase superfamily. It is a probable methyltransferase. Methyltransferase is a type of transferase enzyme which transfers a methyl group from a donor to an acceptor. Often methylation occurs on nucleic bases in DNA or amino acids in protein structures. DNA methylation is often utilized to silence and regulate genes without changing the original DNA sequence. DNA methylation may be necessary for normal growth from embryonic stages in mammals. When mutant embryonic stem cells lacking the murine DNA methyltransferase gene were introduced to a germline of mice they caused a recessive lethal phenotype. Methylation may also be linked to cancer development as methylation of tumor suppressor genes promotes tumorgenesis and metastasis.
仅用于科研。不用于诊断过程。未经明确授权不得转售。
篇参考文献 (0)
生物信息学
蛋白别名: methyltransferase like 7A; methyltransferase like 7A-like; Methyltransferase-like protein 7A; N6-adenosine-methyltransferase TMT1A; Protein AAM-B; Thiol methyltransferase 1A; Thiol S-methyltransferase TMT1A
基因别名: 2210414H16Rik; 3300001H21Rik; AAM-B; METTL7A; PRO0066; RGD1308407; TMT1A; UbiE1; UNQ1902/PRO4348
UniProt ID: (Human) Q9H8H3
Entrez Gene ID: (Human) 25840, (Rat) 315306, (Mouse) 70152